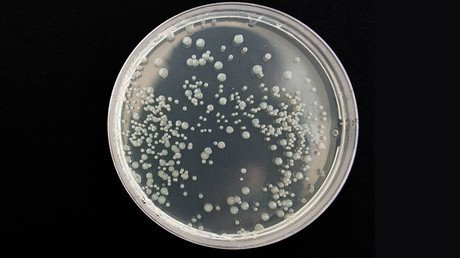
Descubren potentes antibióticos en el cuerpo humano

Científicos de la Universidad Rockefeller, en EE.UU., han descubierto en el cuerpo humano dos nuevos antibióticos muy resistentes a partir del análisis del ADN de bacterias que viven en nuestro organismo. El estudio ha permitido identificar dos potentes antibióticos, Gumimitsina-A y Gumimitsina-B, que podrían contribuir a combatir incluso a las bacterias más resistentes e invulnerables. Asimismo, podrían servir para ampliar y potenciar las nuevas generaciones de medicamentos, según 'Nature Chemical Biology'.
Tras realizar un análisis informático de los genes, que permite buscar en un ADN virtual los microbios y las secuencias de moléculas producidas para destruir las bacterias dañinas, los investigadores detectaron dos proteínas que resultaron ser particularmente eficaces en la lucha contra las bacterias malignas, destruyéndolas e impidiendo la construcción de sus paredes celulares.
Sus funcionamientos se han probado en varios ratones que sobrevivieron con éxito a una infección letal, mientras que el resto del grupo de control, al que no le fueron suministrados los antibióticos, no superó la prueba.
La resistencia a los antibióticos hace que las empresas farmacéuticas tengan que crear más y más tipos de medicamentos. Sin embargo, los microorganismos mutan muy rápidamente, por lo que se vuelven invulnerables a los medicamentos. Si la humanidad dejará de inventar nuevos antibióticos, los existentes hasta la fecha resultarían sencillamente inútiles.
El problema de la resistencia a los antibióticos en todo el mundo genera unos verdaderos centros de investigación de vanguardia, ya que la reproducción de microbios para generar un nuevo antibiótico no es barata. No en vano, el desarrollo de una nueva clase de antibióticos ronda los 800 millones de dólares y, por lo general, tienen una vida útil de entre 8 y 10 años.
Los científicos planean continuar con la investigación con la esperanza de aumentar nuestro arsenal para hacer frente a las enfermedades.